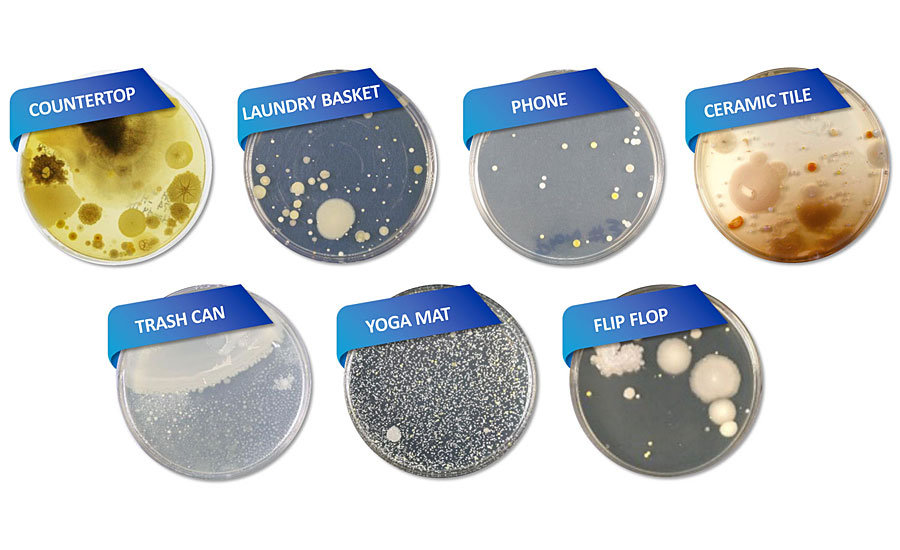

Turnkey Solutions Propelling Antimicrobial Coatings Into the Future

The COVID-19 pandemic put the spotlight on microbes and cleanliness, creating more interest than ever before in antimicrobial coatings. However, bringing new innovations to the industry is not without its challenges, requiring the continual development of novel tools and procedures that can be seamlessly and invisibly incorporated into coatings.
Microbes are found everywhere. These small, living organisms, which include bacteria, molds, fungi, algae and viruses, can rapidly multiply in different environments, making them hard to control in nature. They are frequently found in undesirable locations (Figure 1), where they can cause illnesses, food spoilage, surface stains, bad odors and reduced product life due to contamination or degradation.
Numerous treatments are available that are specifically designed to help reduce the growth and spread of microbes, many of which are tailored for particular environments. However, it is important to note that standard cleaning products, and even surface disinfectants, often have limited residual activity once they dry, especially on high-touch items such as countertops and phones that are used repeatedly on a daily basis. In addition, not all antimicrobials address all types of microorganisms.
One way of addressing these challenges is the implementation of universal lifetime preventive measures that never wear away and inhibit the growth of contaminants, helping to keep surfaces cleaner and fresher for longer. Antimicrobial technologies of this kind can be built into some products at the point of manufacture or, potentially, added in the form of a surface-adherent antimicrobial coating that acts as a barrier to allow the technology to effectively attack and reduce the microbe population. This ‘always on’ protection provides the perfect complement to 24-hour residual cleaning products that are designed to kill 99.9% of surface bacteria during routine cleaning. This helps to maintain surface cleanliness for longer in residential, healthcare and professional environments. The combined use of 24/7 product protection and 24-hour residual cleaning products plays an indispensable role, creating a thorough system of preventive measures to help improve overall environmental cleanliness.
The Way of the Future
The global antimicrobial coatings industry is expected to expand at a compound rate of 13% from 2021 to 2028,1 due in no small part to the COVID-19 pandemic triggering a rapid interest in the application of this technology to coatings. The pandemic has made consumers far more aware of the need for antimicrobial features, not only in homes and workplaces, but also in buildings such as schools and hospitals where cleanliness is critical. With 64% of adults now prepared to pay more for a product with built-in antimicrobial product protection,2 coating developers are acutely aware that the day will come when customers expect this as standard, in the same way that safety airbags have become the norm in modern motor vehicles. Antimicrobial capabilities in coatings will soon be an expectation – rather than something that is ‘nice to have’ – that building specifications in the construction industry will come to demand. As the world emerges from the COVID-19 pandemic, forward-thinking companies that invest in this technology sooner rather than later will benefit from opportunities to differentiate themselves as market leaders and keep well ahead of the curve.
Developing Turnkey Solutions for Today’s World
Companies are beginning to recognize the need to implement a rapid and cost-effective holistic approach to help accelerate the creation of a successful product in a given time period. Across the globe, researchers and engineers have strived to come up with innovations to drive the continuing success of their companies. In the coatings industry, this has resulted in the development of new or improved processes such as mixing, heat and UV curing processes, and application methods ranging from padding for textiles and impregnation, to powder and spray coating. These practices have enabled developers to create new formulations, incorporating additives with properties such as antimicrobial protection for a range of different products, expanding the scope of coatings beyond just paints.
Research and development are just one part of establishing antimicrobial functionality in coating applications. It is equally important to evaluate the short- and long-term consequences of the approach taken in respect of safety and applicable regulations. Navigating the regulatory landscape can be quite challenging, with companies often requiring a great deal of support to categorically ensure that any costly violations or false claims for products are avoided. Each and every antimicrobial coating on the market must comply with all associated regulations – from manufacture and testing to marketing and distribution – across multiple regions, to safeguard both manufacturers and consumers. This situation is further complicated by the fact that every jurisdiction handles antimicrobials differently; some regulate them as chemical substances and others as pesticides or biocidal additives.
Key Considerations of Current Coating Techniques and Processes
Once safety and regulatory compliance is assured, work can begin on finding ways to incorporate antimicrobial additives into the manufacturing process. One way of achieving this is simple addition of antimicrobial agents, but this has many challenges, including material form and appearance, and handling (Figure 2).

Powder or pre-dispersion antimicrobials are often moisture sensitive and easily agglomerate, which limits their shelf and storage life. Dispersions have a tendency to precipitate over time (Figure 3), reducing the amount of active ingredient available in the manufacturing process. However, this can be addressed by high-shear mixing followed by constant agitation once the powder or dispersion has been added to the coating. By the same token, if the additive is too saturated in the mixture, aggregation and sedimentation can lead to undesirable aesthetics and shorten the shelf life of the coating. This can be an even greater challenge when working with thin or high-gloss coatings.

A further complication is that the availability of limited-capacity mixers at the manufacturing site may mean that these steps are not as efficient as they could be, ultimately resulting in wasted materials and unfavorable outcomes that do not meet the regulators’ requirements, which can be very costly for the company. In contrast, using fully integrated antimicrobials with a longer shelf life, that are easier to store and handle, makes the production process more robust. This can also make mixing the different components quicker and cheaper, and is a relatively straightforward approach that can be easily adapted into a more standardized workflow using common industrial grade mixers that are already on site (Figure 4).

Ensuring Compatibility
Once the manufacturing process has been established, attention turns to choosing the most appropriate antimicrobial chemistry for a certain application. The properties of each technology must be fully understood, along with their potential compatibility with the other constituents of the mixture (Figure 5). Key questions need to be asked about the type of system and chemistry before outlining and creating procedures and tools that allow the developers to make very rapid decisions without any guesswork.

Many antimicrobial technologies are based on metals – predominantly silver or zinc. Because of this, the electrochemical impact that the charged ion or dispersing agent would have on the overall system is a significant contributing factor. Antimicrobials that are compatible with a set list of ingredients and a particular application method, where the conditions can be adjusted, are a necessity. This can be more challenging when using water- rather than solvent-based systems. For example, an incorrect charge can cause destabilization of the former but not the latter, and efforts to resolve this issue are ongoing.
Technical parameters, such as viscosity, pH and durability, must be balanced with the consumers’ needs for style, color and finish. This is already a finely tuned and intricate process, and the addition of even more technologies further increases the complexity. Water chemistries are inherently less robust and less effective at accepting a suite of ingredients than their solvent-based counterparts, and entirely different constraints must be considered. The effect of other ingredients that provide additional benefits, like resistance to abrasion and sunlight or stabilization to UV, must also be carefully thought through.
Along with some of these technical parameters, powder coatings present unique processing challenges that require careful antimicrobial selection. High processing temperatures, UV exposure and order of addition are integral to ensuring effective incorporation of the antimicrobial treatment without negatively impacting the coat’s finish or mechanical resistance.
Looking to the Future
As the industry looks to the future, the goal is to establish a broad portfolio of turnkey antimicrobial surface solutions that can be seamlessly and invisibly added to any coating. Coatings manufacturers will benefit from the development of effective tools and processes to overcome the current production challenges, enabling the inclusion of antimicrobial solutions without impacting the desired aesthetics and performance properties of the end products. A large proportion of ongoing research into new antimicrobial treatments is focused on systems that combine different chemistries for a more diverse group of substrates, such as fabrics, metals, vinyl and wood. Amidst the COVID-19 pandemic, these have already been introduced into silicone coatings for phone cases, transparent coatings for screen protectors, glazed coatings for ceramic tiles, powder coatings for door hardware, water-based coatings for floor cleaning, solvent-based coatings for metals and urethane coatings for a high-gloss finish. It is pretty much a given that, within just a few years, inclusion of antimicrobials in coatings will be an expectation and not an optional extra.
References
¹ Grand View Research. (2021). Global Antimicrobial Coatings Market Size Report, 2021-2028. Available at: www.grandviewresearch.com/industry-analysis/antimicrobial-coatings-market
² Multi-sponsor surveys. (2020). Antibacterial Products Study
Looking for a reprint of this article?
From high-res PDFs to custom plaques, order your copy today!







